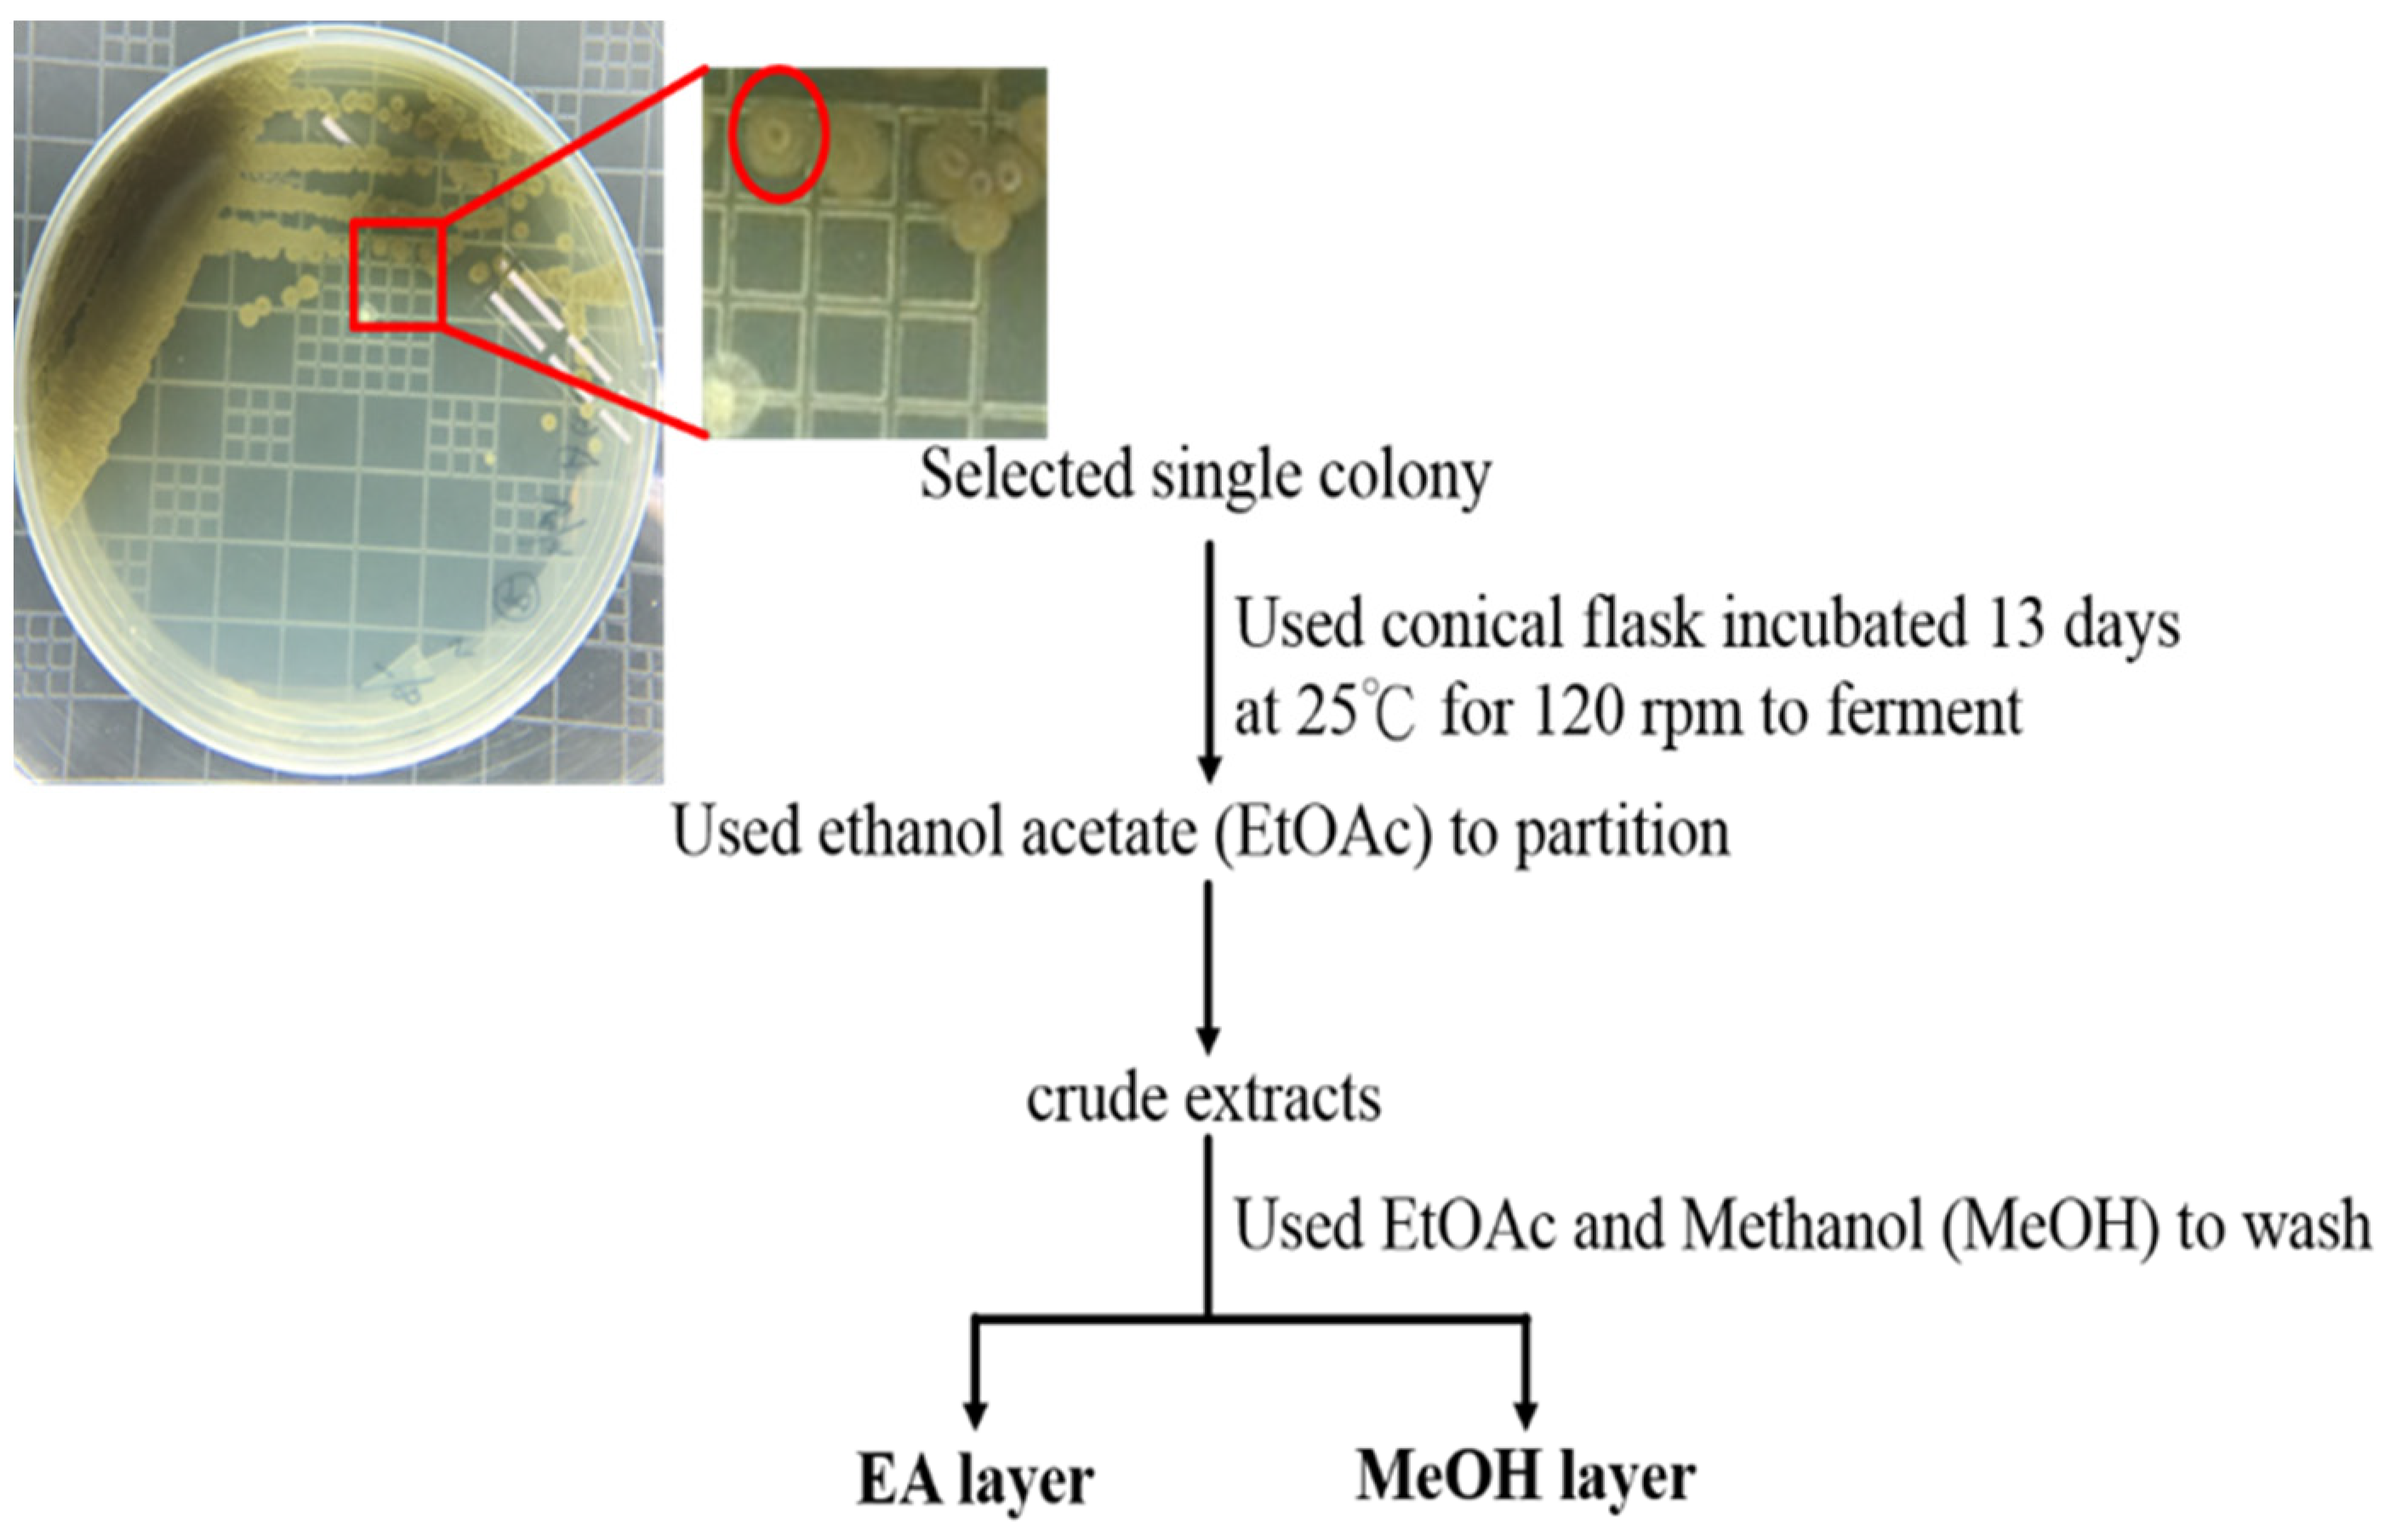
Life 11 01414 g001

The Anti-Proliferative Activity of Secondary Metabolite from the Marine Streptomyces sp. against Prostate Cancer Cells
Abstract
:1. Introduction
2. Materials and Methods
2.1. Cell Culture and Chemicals
2.2. 16S rDNA Sequencing
2.3. Cell Culture
2.4. MTT Assay
2.5. Colony Formation Assay
2.6. Wound Healing Assay
2.7. Western Blotting
2.8. Cell Cycle
2.9. Mitochondrial Membrane Potential
2.10. Immunofluorescence Assay
2.11. Statistics
3. Results
3.1. Separation of Bacteria and Metabolites with Antibacterial Activity from Marine Sediments
3.2. Lu01-M Exhibited Anti-Proliferative Activity and Induced Cell Apoptosis in Prostate Cancer Cell Lines
3.3. Lu01-M Inhibited Colony Formation and Cell Migration in Prostate Cancer PC3 Cell Lines
3.4. Lu01-M Induced Cell Cycle G2/M Phase Arrest in PC3 Prostate Cancer Cell Lines
3.5. Lu01-M Induced Mitochondrial Dysfunction and ER Stress in PC3 Prostate Cancer Cell Lines
3.6. Lu01-M Caused DNA Damage in Human Prostate Cancer PC3 Cells
3.7. Lu01-M Caused Necroptosis in Human Prostate Cancer PC3 Cells
3.8. L01-M-Induced Cell Autophagy Promoting Cell Survival Response in Human Prostate Cancer PC3 Cells
4. Discussion
5. Conclusions
Author Contributions
Funding
Institutional Review Board Statement
Data Availability Statement
Acknowledgments
Conflicts of Interest
References
- Ruiz-Torres, V.; Encinar, J.A.; Herranz-Lopez, M.; Perez-Sanchez, A.; Galiano, V.; Barrajon-Catalan, E.; Micol, V. An updated review on marine anticancer compounds: The use of virtual screening for the discovery of small-molecule cancer drugs. Molecules 2017, 22, 1037. [Google Scholar] [CrossRef] [PubMed]
- Blunt, J.W.; Copp, B.R.; Keyzers, R.A.; Munro, M.H.; Prinsep, M.R. Marine natural products. Nat. Prod. Rep. 2014, 31, 160–258. [Google Scholar] [CrossRef] [PubMed] [Green Version]
- Kulbicki, M.; Parravicini, V.; Bellwood, D.R.; Arias-Gonzàlez, E.; Chabanet, P.; Floeter, S.R.; Friedlander, A.; McPherson, J.; Myers, R.E.; Vigliola, L.; et al. Global biogeography of reef fishes: A hierarchical quantitative delineation of regions. PLoS ONE 2013, 8, e81847. [Google Scholar] [CrossRef]
- Morita, M.; Schmidt, E.W. Parallel lives of symbionts and hosts: Chemical mutualism in marine animals. Nat. Prod. Rep. 2018, 35, 357–378. [Google Scholar] [CrossRef]
- Valdiglesias, V.; Prego-Faraldo, M.V.; Pásaro, E.; Méndez, J.; Laffon, B. Okadaic acid: More than a diarrheic toxin. Mar. Drugs 2013, 11, 4328–4349. [Google Scholar] [CrossRef] [Green Version]
- Cuevas, C.; Perez, M.; Martin, M.J.; Chicharro, J.L.; Fernandez-Rivas, C.; Flores, M.; Francesch, A.; Gallego, P.; Zarzuelo, M.; De La Calle, F.; et al. Synthesis of ecteinascidin ET-743 and phthalascidin Pt-650 from cyanosafracin B. Org. Lett. 2000, 2, 2545–2548. [Google Scholar] [CrossRef]
- Campos, A.; Clemente-Blanco, A. Cell Cycle and DNA Repair Regulation in the Damage Response: Protein Phosphatases Take Over the Reins. Int. J. Mol. Sci. 2020, 21, 446. [Google Scholar] [CrossRef] [Green Version]
- D’Arcy, M.S. Cell death: A review of the major forms of apoptosis, necrosis and autophagy. Cell Biol. Int. 2019, 43, 582–592. [Google Scholar] [CrossRef]
- Sung, H.; Ferlay, J.; Siegel, R.L.; Laversanne, M.; Soerjomataram, I.; Jemal, A.; Bray, F. Global Cancer Statistics 2020: GLOBOCAN Estimates of Incidence and Mortality Worldwide for 36 Cancers in 185 Countries. CA Cancer J. Clin. 2021, 71, 209–249. [Google Scholar] [CrossRef]
- De Bono, J.S.; Oudard, S.; Ozguroglu, M.; Hansen, S.; Machiels, J.P.; Kocak, I.; Gravis, G.; Bodrogi, I.; Mackenzie, M.J.; Shen, L.; et al. Prednisone plus cabazitaxel or mitoxantrone for metastatic castration-resistant prostate cancer progressing after docetaxel treatment: A randomised open-label trial. Lancet 2010, 376, 1147–1154. [Google Scholar] [CrossRef]
- Kantoff, P.W.; Higano, C.S.; Shore, N.D.; Berger, E.R.; Small, E.J.; Penson, D.F.; Redfern, C.H.; Ferrari, A.C.; Dreicer, R.; Sims, R.B.; et al. Sipuleucel-T immunotherapy for castration-resistant prostate cancer. N. Engl. J. Med. 2010, 363, 411–422. [Google Scholar] [CrossRef] [PubMed] [Green Version]
- De Bono, J.S.; Logothetis, C.J.; Molina, A.; Fizazi, K.; North, S.; Chu, L.; Chi, K.N.; Jones, R.J.; Goodman, O.B., Jr.; Saad, F.; et al. Abiraterone and increased survival in metastatic prostate cancer. N. Engl. J. Med. 2011, 364, 1995–2005. [Google Scholar] [CrossRef] [PubMed]
- Scher, H.I.; Fizazi, K.; Saad, F.; Taplin, M.E.; Sternberg, C.N.; Miller, K.; De Wit, R.; Mulders, P.; Chi, K.N.; Shore, N.D.; et al. Increased survival with enzalutamide in prostate cancer after chemotherapy. N. Engl. J. Med. 2012, 367, 1187–1197. [Google Scholar] [CrossRef] [PubMed] [Green Version]
- Das, G.; Shravage, B.V.; Baehrecke, E.H. Regulation and function of autophagy during cell survival and cell death. Cold Spring Harb. Perspect. Biol. 2012, 4, a008813. [Google Scholar] [CrossRef] [Green Version]
- Subramani, R.; Aalbersberg, W. Marine actinomycetes: An ongoing source of novel bioactive metabolites. Microbiol. Res. 2012, 167, 571–580. [Google Scholar] [CrossRef]
- Li, X.; Darzynkiewicz, Z. Cleavage of Poly(ADP-ribose) polymerase measured in situ in individual cells: Relationship to DNA fragmentation and cell cycle position during apoptosis. Exp. Cell Res. 2000, 255, 125–132. [Google Scholar] [CrossRef]
- Li, J.; Lee, A.S. Stress induction of GRP78/BiP and its role in cancer. Curr. Mol. Med. 2006, 6, 45–54. [Google Scholar] [CrossRef]
- Martucciello, S.; Masullo, M.; Cerulli, A.; Piacente, S. Natural Products Targeting ER Stress, and the Functional Link to Mitochondria. Int. J. Mol. Sci. 2020, 21, 1905. [Google Scholar] [CrossRef] [Green Version]
- Abbas, T.; Dutta, A. p21 in cancer: Intricate networks and multiple activities. Nat. Rev. Cancer 2009, 9, 400–414. [Google Scholar] [CrossRef]
- Sheppard, K.E.; Pearson, R.B.; Hannan, R.D. Unexpected role of CDK4 in a G2/M checkpoint. Cell Cycle 2015, 14, 1351–1352. [Google Scholar] [CrossRef] [Green Version]
- Fernandez-Capetillo, O.; Chen, H.T.; Celeste, A.; Ward, I.; Romanienko, P.J.; Morales, J.C.; Naka, K.; Xia, Z.; Camerini-Otero, R.D.; Motoyama, N.; et al. DNA damage-induced G2-M checkpoint activation by histone H2AX and 53BP1. Nat. Cell Biol. 2002, 4, 993–997. [Google Scholar] [CrossRef]
- Al-Lamki, R.S.; Lu, W.; Manalo, P.; Wang, J.; Warren, A.Y.; Tolkovsky, A.M.; Pober, J.S.; Bradley, J.R. Tubular epithelial cells in renal clear cell carcinoma express high RIPK1/3 and show increased susceptibility to TNF receptor 1-induced necroptosis. Cell Death Dis. 2016, 7, e2287. [Google Scholar] [CrossRef] [Green Version]
- Wu, Z.Z.; Zhang, J.J.; Gao, C.C.; Zhao, M.; Liu, S.Y.; Gao, G.M.; Zheng, Z.H. Expression of autophagy related genes mTOR, Becline-1, LC3 and p62 in the peripheral blood mononuclear cells of systemic lupus erythematosus. Am. J. Clin. Exp. Immunol. 2017, 6, 1–8. [Google Scholar]

| Strain | Activity Against (mm) | |
|---|---|---|
| Staphylococcus aureus | Bacillus subtilis | |
| Ac | - | 4.3 |
| Lu01 | 1.3 | - |
| Ah | 20.3 | 15.6 |
| Bi | - | 11.3 |
| Db | - | * |
| De | * | - |
| Strain | Accession No. | Description | % Identity |
|---|---|---|---|
| Ac | NR_041213.1 NR_043490.1 | Streptomyces pulveraceus Streptomyces atratus | 99 99 |
| Lu01 | KM370054.1 KF793806.1 | Streptomyces sp. FoRh86 Streptomyces sp. SW4 | 99 99 |
| Ah | KF287177.1 X87320.1 | Streptomyces sp. PN1018 Streptomycetaceae | 100 99 |
| Bi | NR_029370.1 NR_027229.1 | Saccharomonosporaazurea Saccharomonospora glauca | 100 99 |
Publisher’s Note: MDPI stays neutral with regard to jurisdictional claims in published maps and institutional affiliations. |
© 2021 by the authors. Licensee MDPI, Basel, Switzerland. This article is an open access article distributed under the terms and conditions of the Creative Commons Attribution (CC BY) license (https://creativecommons.org/licenses/by/4.0/).
Share and Cite
Lin, H.-Y.; Lin, Y.-S.; Shih, S.-P.; Lee, S.-B.; El-Shazly, M.; Chang, K.-M.; Yang, Y.-C.S.H.; Lee, Y.-L.; Lu, M.-C. The Anti-Proliferative Activity of Secondary Metabolite from the Marine Streptomyces sp. against Prostate Cancer Cells. Life 2021, 11, 1414. https://doi.org/10.3390/life11121414
Lin H-Y, Lin Y-S, Shih S-P, Lee S-B, El-Shazly M, Chang K-M, Yang Y-CSH, Lee Y-L, Lu M-C. The Anti-Proliferative Activity of Secondary Metabolite from the Marine Streptomyces sp. against Prostate Cancer Cells. Life. 2021; 11(12):1414. https://doi.org/10.3390/life11121414
Chicago/Turabian StyleLin, Hung-Yu, Yong-Shiou Lin, Shou-Ping Shih, Sung-Bau Lee, Mohamed El-Shazly, Ken-Ming Chang, Yu-Chen S. H. Yang, Yi-Lun Lee, and Mei-Chin Lu. 2021. "The Anti-Proliferative Activity of Secondary Metabolite from the Marine Streptomyces sp. against Prostate Cancer Cells" Life 11, no. 12: 1414. https://doi.org/10.3390/life11121414
APA StyleLin, H.-Y., Lin, Y.-S., Shih, S.-P., Lee, S.-B., El-Shazly, M., Chang, K.-M., Yang, Y.-C. S. H., Lee, Y.-L., & Lu, M.-C. (2021). The Anti-Proliferative Activity of Secondary Metabolite from the Marine Streptomyces sp. against Prostate Cancer Cells. Life, 11(12), 1414. https://doi.org/10.3390/life11121414

